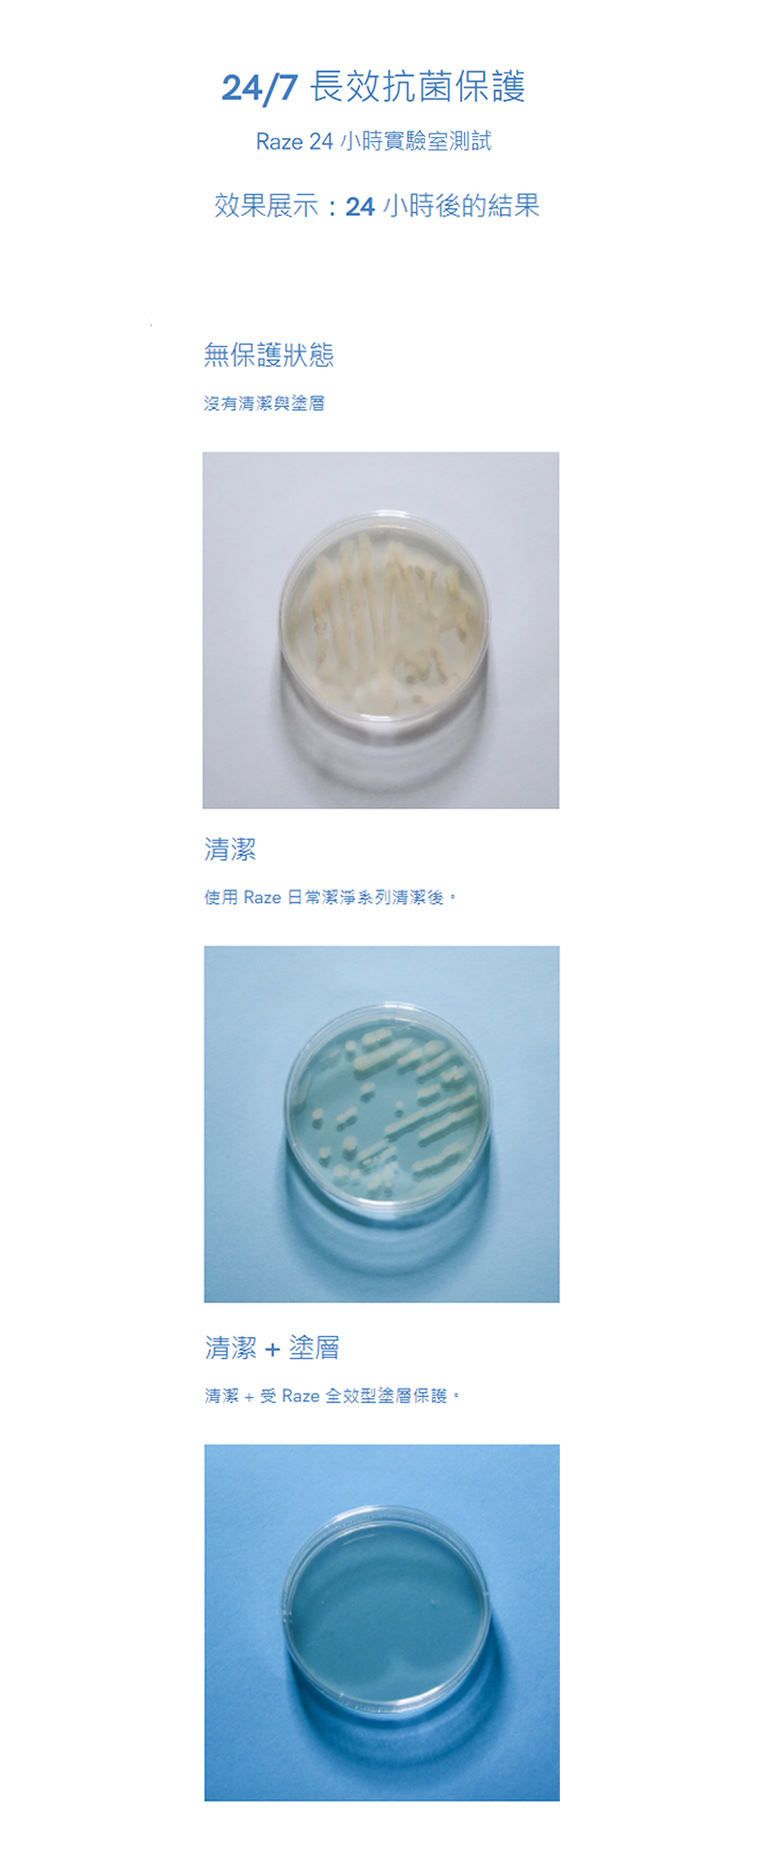

{{ 'fb_in_app_browser_popup.desc' | translate }} {{ 'fb_in_app_browser_popup.copy_link' | translate }}
{{ 'in_app_browser_popup.desc' | translate }}
🎉🎉運送台灣【限時免運費!】*優惠至2025年9月30日*
春季大促【💝49折起】特惠專區👉進內繼續挑選其他特惠貨品同享購得 >> (數量有限,購完即止!)
{{ childProduct.title_translations | translateModel }}
{{ getChildVariationShorthand(childProduct.child_variation) }}
{{ getSelectedItemDetail(selectedChildProduct, item).childProductName }} x {{ selectedChildProduct.quantity || 1 }}
{{ getSelectedItemDetail(selectedChildProduct, item).childVariationName }}
認證 :
有效殺滅新型冠狀病毒>99%
有效殺滅病毒及細菌等病原體>99%
有效淨化甲醛及有機化合物>90%
有效抑制霉菌生長長達28天
特點:
持續殺滅包括新型冠狀病毒及細菌等病原體超過99%*
消除揮發性有機化合物 (甲醛) 及臭味,淨化室內空氣
革命性納米級光觸媒隱形塗層,比傳統光觸媒細5倍
深入物體細微罅隙形成長效結構塗層,有效期高達3個月
室內光線即能激活殺滅反應,無需光源長期照射,晝夜無間發揮效能
不含腐蝕性化學物,適用於大部份表面,不損害效能及外觀
不含有害物質、酒精及香料,適合育有兒童及寵物之家庭環境
特配霧化式噴頭,均勻釋出超微細分子
配合RAZE UV 激活底座使用
全店,📍✈全球運送✈【滿HKD$400香港本地*免運費*】會員結帳可再享95折~88折(部份商品)
以優惠價加購商品 (最多 {{ addItemQuantity }} 件)
售完
您所填寫的商品數量超過庫存
{{'products.quick_cart.out_of_number_hint'| translate}}
{{'product.preorder_limit.hint'| translate}}
每筆訂單限購 -1 件
{{'products.quick_cart.quantity_of_stock_hint'| translate : {message: quantityOfStock} }}